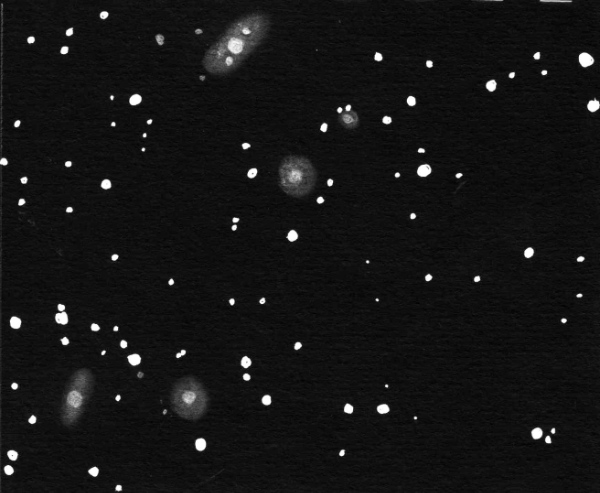
Sketch of NGC 2289 galaxy group and NGC 2486 in Gemini by Dale Holt from his Chippingdale observatory in Hertfordshire

IC Galaxies around NGC 2340
On you Webb Society web site you talk about NGC 2340 and the other nearby galaxies. Then you ask for some input. I checked my old observations and I will give them below. I did not include the two brighter galaxies NGC 2332 & 2340.
IC 458
3/28/87 17.5" 12mm
Seen w/ direct vision, roundish, diffuse, similar in size & slightly fainter than IC 464, brighter than IC 461, star very close to southern tip.
3/16/91 12.5" 12mm
Direct vision, roundish, diffuse, star on southern tip.
1/10/2000 12.5" 12mm
AV/1, slightly ellip, diffuse, even brightness throughout,
star on southern tip.
IC 459
3/28/87 17.5" 12mm
NOT SEEN
IC 460
3/28/87 17.5" 12mm
AV/1 best, appears almost star-like, very faint thin diffuseness surrounds a brighter very compact core.
1/10/2000 12.5" 12mm
AV/2, very close to a star on it's NP edge which tends to "wash out" this galaxy. It is small, round, diffuse, even brightness throughout.
IC 461
3/28/87 17.5" 12mm
AV/1, very diffuse patch of light, even brightness throughout. There is a faint star following which is brighter than the galaxy.
IC 464
3/28/87 17.5" 12mm, 10mm.
12mm= Direct Vision, elliptical, possibly very gradually brighter towards the middle. 10mm= I now see a very compact little brighter core.
3/16/91 12.5" 12mm
Direct vision but faint, roundish, diffuse, brighter very compact core.
1/10/2000 12.5" 16mm
While observing NGC 2340 I soon noticed IC 464 in my field. It was
seen with AV/1, a little elliptical shaped, diffuse, very small, patch of
light, has a slightly brighter star-like core which "comes & goes".
IC 465
3/28/87 17.5" 12mm
Direct Vision, slightly elliptical, diffuse, even brightness throughout, about the same size as IC 464 but slightly brighter.
3/16/91 12.5" 12mm
AV/1, small, round, diffuse envelope surrounds a slightly brighter star-like core.
Ron Morales - (19 February 2016).